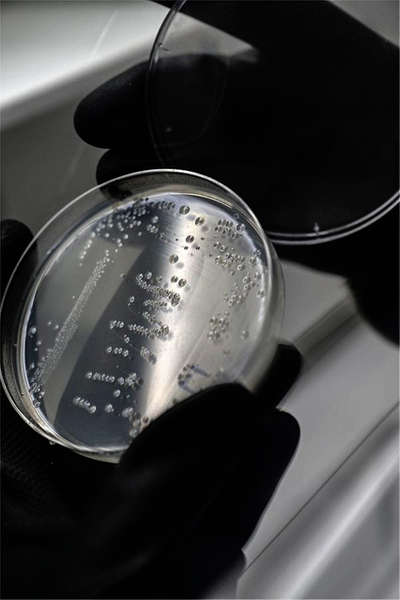

发布日期:
安农大团队分离出新型菌株攻克磺胺类抗生素污染
文章字数:463

记者1月21日从安徽农业大学获悉,该校资源与环境学院吴祥为教授团队日前在环境科学与水资源领域获得新进展,成功分离出一种能在无氧条件下高效降解磺胺类抗生素的菌株,为解决此类污染物带来的环境难题提供了新方案。相关成果在国际期刊《水研究》上发表。
磺胺甲恶唑是常用的磺胺类抗生素,广泛用于畜禽养殖、医疗业预防和治疗细菌性感染的疾病,但在生物体内难以代谢,大量使用后易进入环境导致残留污染、诱发细菌抗药性并增加抗生素抗性基因传播风险。
安农大科研团队首次揭开了无氧环境下微生物降解这类抗生素的分子机制,为污水治理、土壤修复等无氧或低氧环境中的磺胺类抗生素污染治理,提供了重要的理论支持和实用技术。
“我们团队首次分离获得这种厌氧菌,它能够用于修复磺胺类抗生素残留污染,与传统的物理和化学修复技术相比,微生物修复具有修复彻底、无二次污染和成本低廉的优点。”安农大资源与环境学院副教授刘军委介绍。据了解,新型菌株利用多种物质生长并提供能量,通过打破抗生素分子中的多种化学反应实现对磺胺类抗生素的降解。
(安徽日报记者 陈婉婉 徐旻昊 实习生 何蓝蓝 吴瑞睿)
